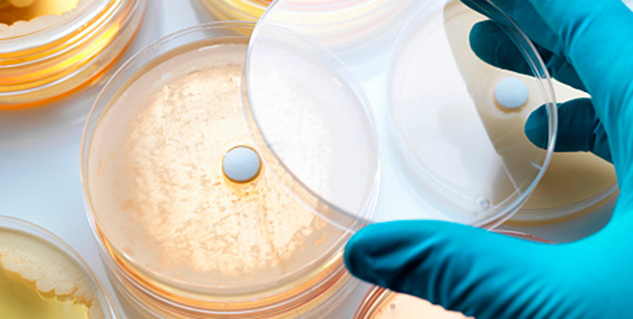
antibiotic antibiotic

एंटीबॉयोटिक दवाओं के आविष्कार ने मेडिकल जगत में क्रांति ला दिया और चिकित्सा आसान हो गया। लेकिन धीरे-धीरे इस दवा के प्रति लोग इतने आसक्त होते गये कि हर समस्या का उपचार इस दवा में देखने लगे। विभिन्न शोधों की मानें तो आम इंसान ही नहीं बहुत सारे चिकित्सक भी एंटीबॉयोटिक दवाओं को अधिक महत्व देने लगे। एक तरफ जहां इस दवा ने उपचार को आसान बनाया वहीं दूसरी तरफ इसके अधिक सेवन से स्थिति और बदतर होने लगी। आज दुनियाभर के बाजार में 60 हजार से भी अधिक नामों से एंटिबॉयोटिक दवायें मौजूद हैं, जबकि डब्यूएचओ ने मात्र 160 दवाओं को ही वैध माना है। फिलहाल इस लेख में हम आपको बता रहे हैं कि अगर एंटीबॉयटिक दवाओं का अधिक सेवन किया जाये तो क्या हो सकता है।
इसे भी पढ़ें: जानिए क्या हैं हृदय रोग के लक्षण
क्या है एंटीबॉयिटिक
एंटीबॉयोटिक एक ग्रीक शब्द है, एंटी (विरोध) और बायोस (जीवन) से मिलकर बना है। चूंकि जीवाणुओं को जीवन की प्राथमिक अवस्था माना जाता है। ऐसे में एंटीबॉयोटिक का मतलब जीवन यानी बैक्टीरिया का विरोध करने वाली चीज है। यह जीवाणुओं के विकास को रोकता है। यानी यह बैक्टीरिया के संक्रमण को रोककर उपचार में सहायक है।
भारत की स्थिति
एंटीबॉयटिक दवाओं के अधिक सेवन के मामले और इससे दुष्परिणाम के चौंकाने वाले तथ्य भारत से आये हैं। डब्यूएचओ द्वारा किये गये शोध की मानें तो भारत में किसी भी बीमारी के उपचार में अधिक से अधिक दवायें एंटीबॉयटिक के रूप में दी जाती हैं। इसके कारण भारत में टीबी जैसी बीमारी और अधिक भयावह होती जा रही है। भारत के 50 फीसदी से ज्यादा लोग दवाओं के नकारात्मक असर का ध्यान नहीं रखते और डॉक्टर से परामर्श लिए बिना एंटीबायोटिक दवाओं का सेवन करते हैं। 2010 में भारत एंटीबॉयोटिक के सेवन के मामले में नंबर एक पर था। इस दौरान भारत में 1300 करोड़ स्टैंडर्ड यूनिट (डोज), चीन में 1000 करोड़ और अमेरिका में 700 करोड़ स्टैंडर्ड यूनिट एंटीबायोटिक दवाओं की खपत हुई।
टीबी के उपचार में बेअसर
भारत में साल 2010 में टीबी के 4 लाख 40 हजार नये मामले सामने आये, जिनपर एंटीबॉयोटिक का कोई असर नहीं दिखा, इसके कारण 1.5 लाख लोगों की मौत भी हो गई। पूरी दुनिया में इसके कारण लगभग 7 लाख लोगों की मौतें होती हैं। एक अनुमान की मानें तो अगर 2050 तक इसके अधिक उपयोग को नहीं रोका गया तो मरने वालों की संख्या हर साल एक करोड़ तक हो सकती है।
बच्चों के लिए नुकसानदेह
बच्चों को सबसे अधिक संक्रमण की समस्या होती है। इसके उपचार में एंटीबॉयटिक दवाओं का प्रयोग चिकित्सक भी अधिक करते हैं, जिसका असर उल्टा होने लगता है। इसके कारण बच्चों को डायरिया भी हो सकता है।
एंटीबॉयोटिक से दूसरी समस्यायें
जरूरत से ज्यादा अगर एंटीबॉयटिक दवाओं का सेवन किया जाये तो ड्रग रेजिस्टेंट का खतरा हो जाता है। इसके कारण यह बैक्टीरिया पर बेअसर हो जाता है। इसके अलावा डायरिया, कमजोरी, मुंह में संक्रमण, पाचन तंत्र में कमजोरी, योनि में संक्रमण होने का भी खतरा रहता है। किडनी में स्टोन, खून का थक्का बनना, सुनने में समस्या और एलर्जी जैसी शिकायत होने लगती है।
इसलिए चिकित्सक की सलाह के बिना एंटीबॉयिटक दवाओं का सेवन न करें, खासकर गर्भवती महिलायें और लीवर के मरीज डॉक्टर से पूछे बिना इनका सेवन न करें।
ऐसे अन्य स्टोरीज के लिए डाउनलोड करें: ओनलीमायहेल्थ ऐप
Image Source : Getty
Read More Articles on Miscellaneous in Hindi
How we keep this article up to date:
We work with experts and keep a close eye on the latest in health and wellness. Whenever there is a new research or helpful information, we update our articles with accurate and useful advice.
Current Version